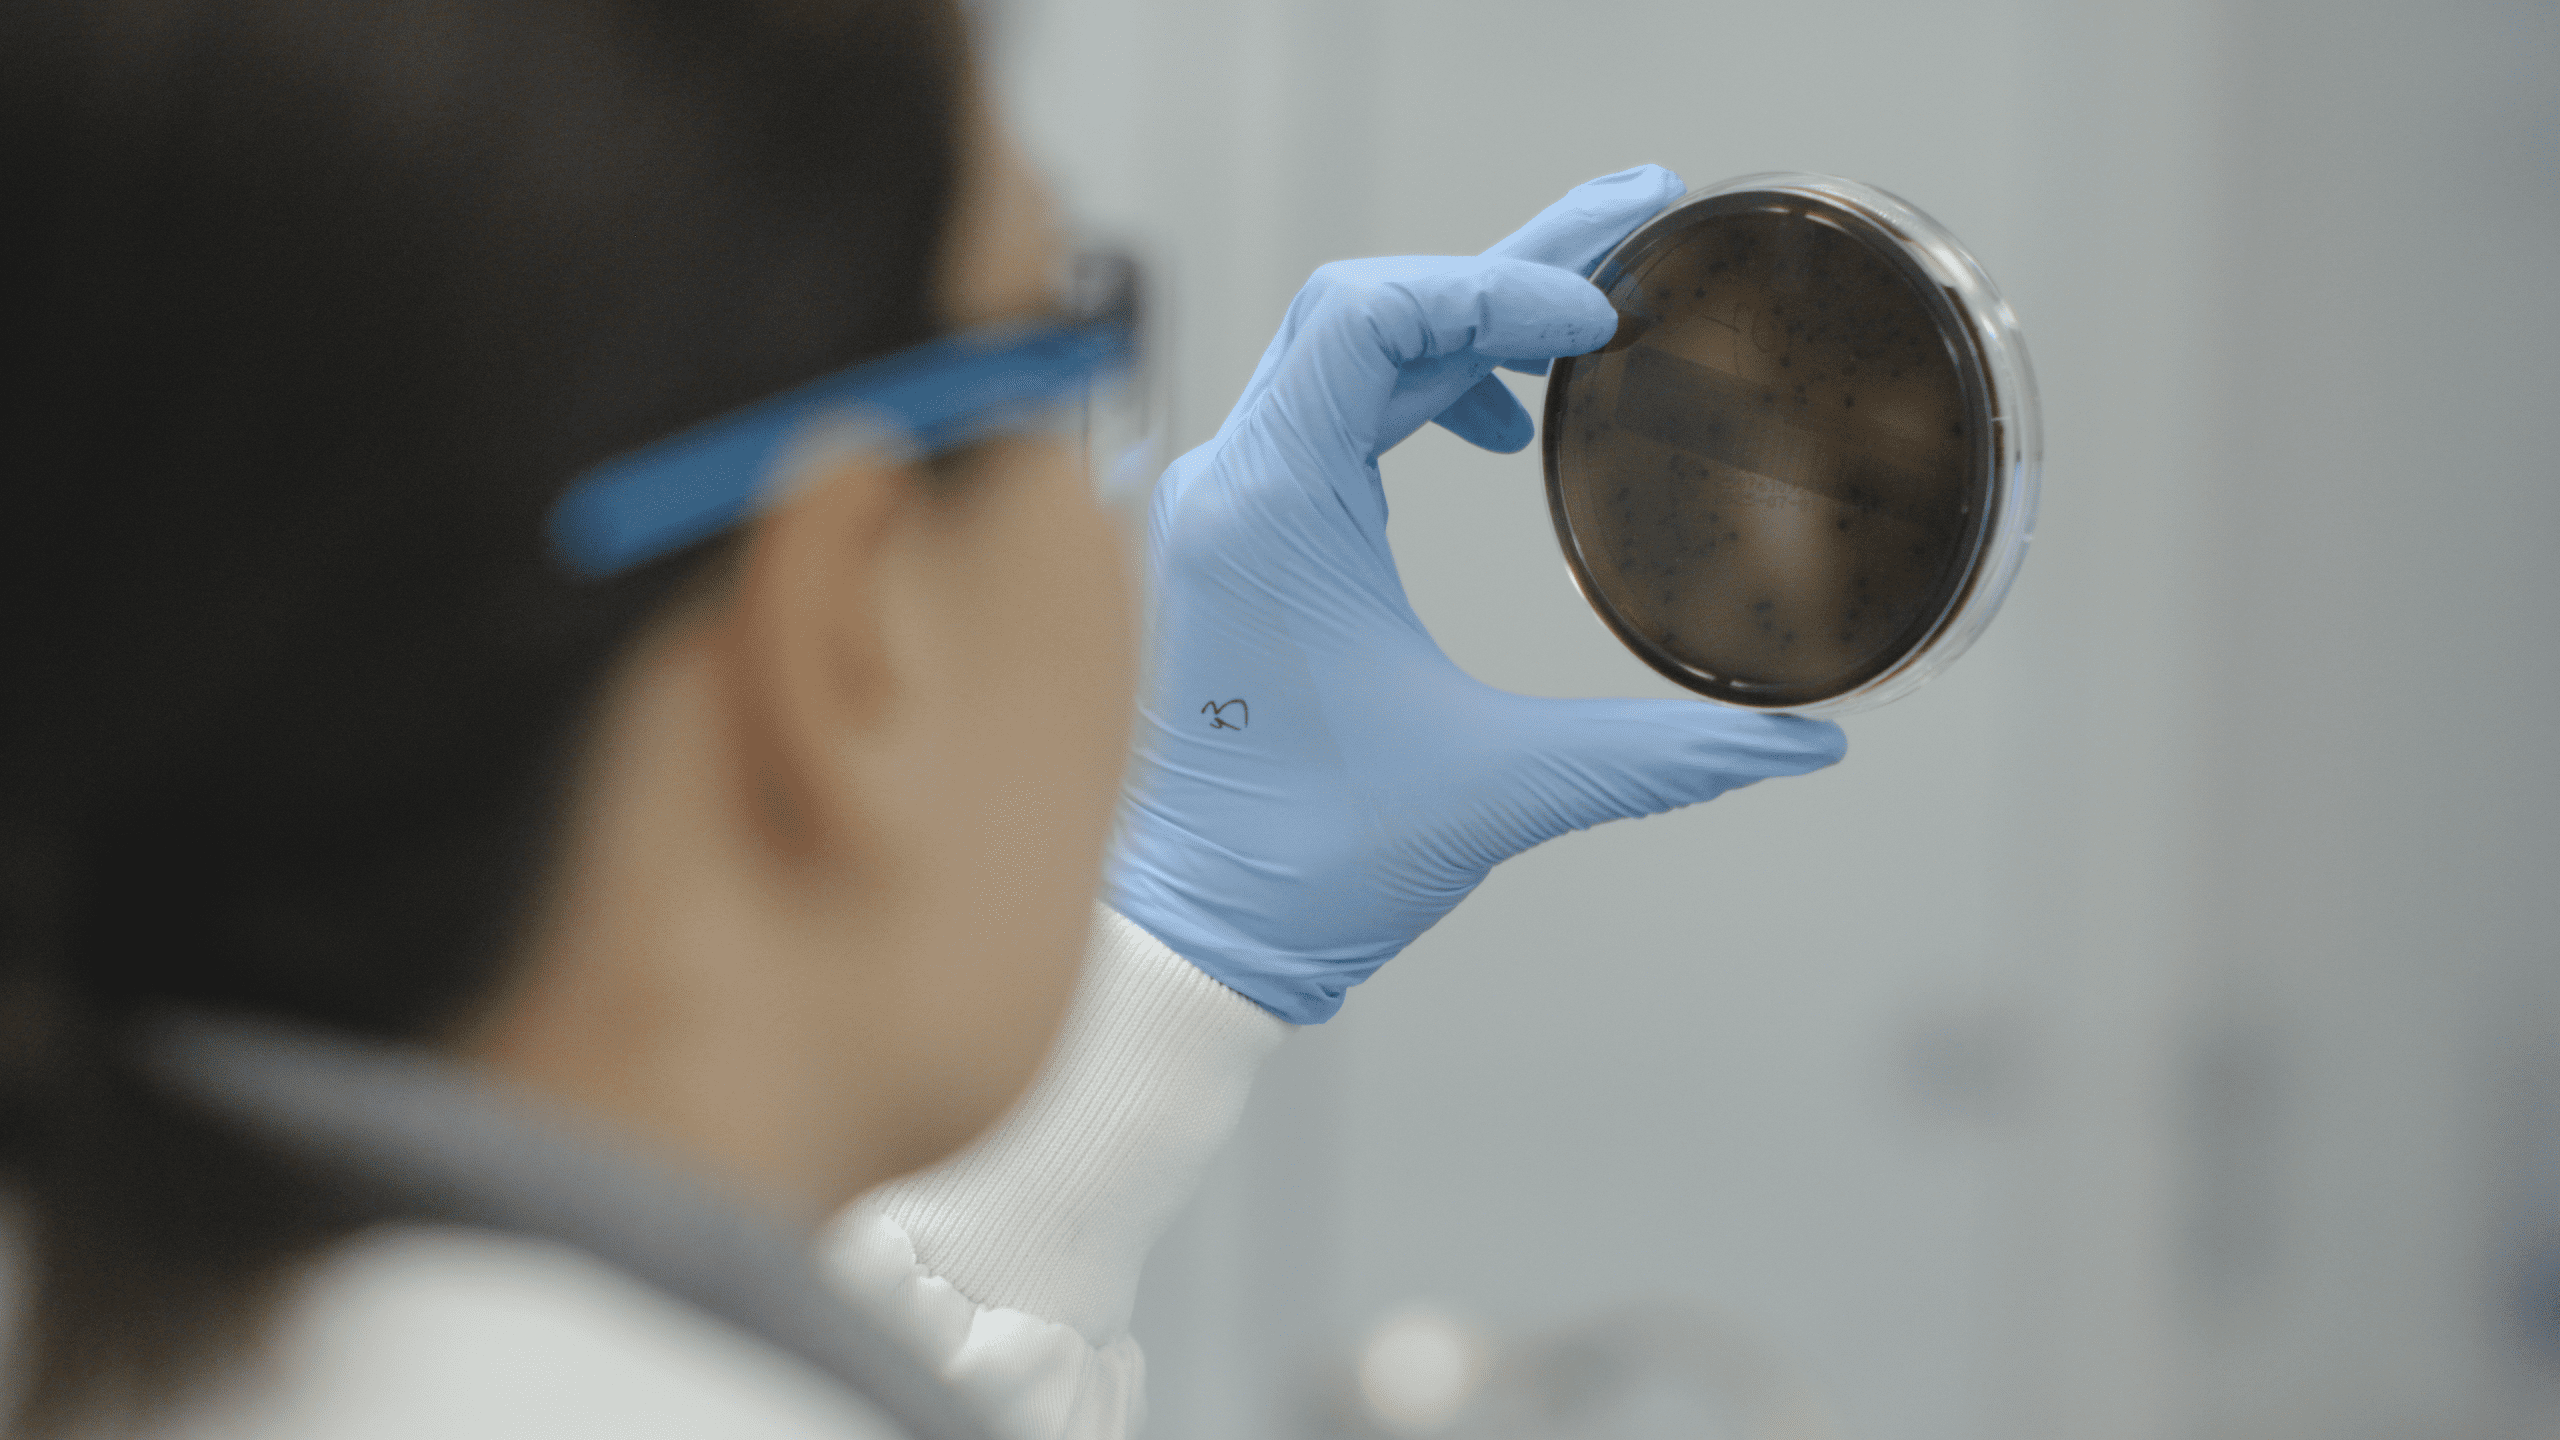
Lab analyses

Overzicht van al onze diensten
Als ketenpartner levert Peterson geïntegreerde diensten op het gebied van logistiek, inspecties, consultancy, technologie en training. Praktische oplossingen die zorgen voor grip, compliance en duurzame vooruitgang.

- Digitale oplossingen & duurzaamheidsadvies
- Haven & terminal
- Lab analyses, inspecties & certificeringen
- Opslag & voorraad
- Planning & coördinatie
- Transport & distributie
Digitale oplossingen & duurzaamheidsadvies
Meer over Digitale oplossingen & duurzaamheidsadviesLab analyses, inspecties & certificeringen
Meer over Lab analyses, inspecties & certificeringenOpslag & voorraad
Meer over Opslag & voorraadPlanning & coördinatie
Meer over Planning & coördinatieTransport & distributie
Meer over Transport & distributieOnze supply chain experts staan klaar
Een offerte aanvragen of vrijblijvend supply chain mogelijkheden bespreken? Dat kan altijd. Vul onderstaand formulier in en we nemen z.s.m. contact op.

"*" geeft vereiste velden aan